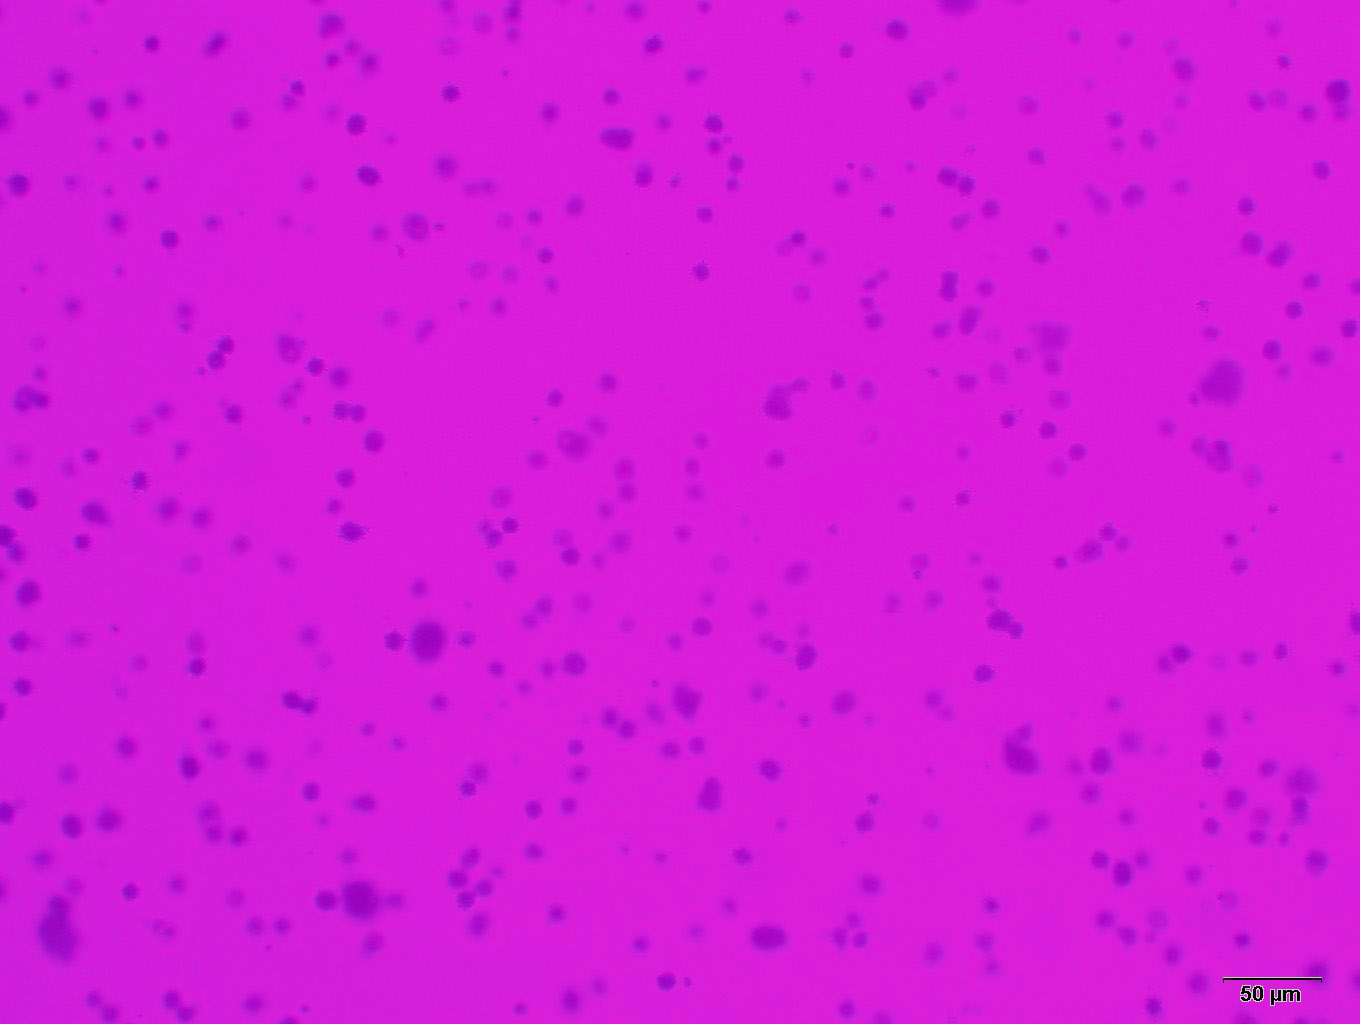

细胞接种存活率只表示接种细胞后贴壁的细胞数,但贴壁后的细胞不一定每个都能增殖和形成克隆。而形成克隆的细胞必为贴壁和有增殖活力的细胞。克隆形成率反映细胞群体依赖性和增殖能力两个重要性状。
由于细胞生物学性状不同,细胞克隆形成率差别也很大,一般初代培养细胞克隆形成率弱,传代细胞系强;二倍体细胞克隆形成率弱,转化细胞系强;正常细胞克隆形成率弱,肿瘤细胞强。并且克隆形成率与接种密度有一定关系,做克隆形成率测定时,接种细胞一定要分散成单细胞悬液,直接接种在碟皿中,持续一周,随时检查,到细胞形成克隆时终止培养。
 欢迎来到乐鱼网页版登录入口网站!
欢迎来到乐鱼网页版登录入口网站! 欢迎来到乐鱼网页版登录入口网站!
欢迎来到乐鱼网页版登录入口网站!